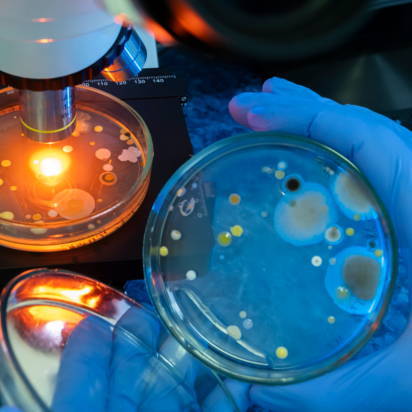

Consumer Goods Testing Services
Provides laboratory based testing and assessment to verify that consumer products are safe, compliant & fit for use

Provides laboratory based testing and assessment to verify that consumer products are safe, compliant & fit for use
Food Additives:
Chemical Contaminants:
Food Packaging:
Shelf-Life & Stability Testing:
Product Sensory
Chemical Residue:
Nutrition Content:
Multivitamins, etc.
Microbiology: